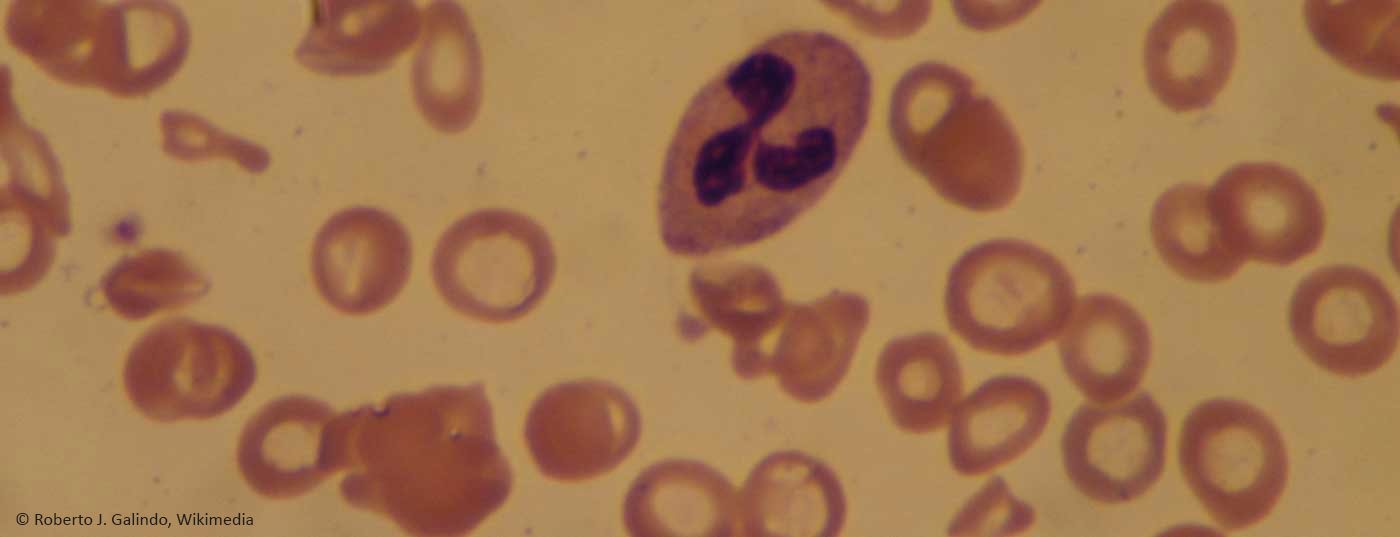
eisenmangelanaemie

Eisen ist für verschiedene biochemische und physiologische Funktionen essenziell. Eisenmangel ist weit verbreitet und eine der Hauptursachen für Anämie. Als Prophylaxe ist eine ausreichende Versorgung mit Ferritin über die Ernährung wichtig. Bei Vorliegen eines Eisenmangels kann oral oder intravenös substituiert werden, wobei Wirksamkeit und Verträglichkeit individuell unterschiedlich sind.